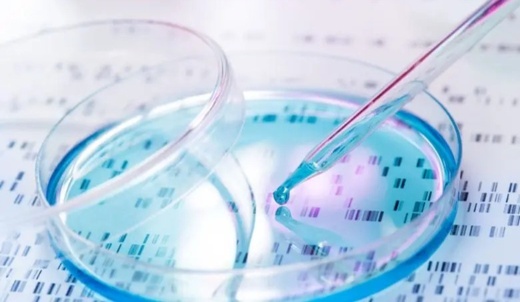
حقوقي لناظور سيتي: تجاهل اعتماد ال ADN لإثبات النسب انتهاك لحقوق فئة مهمة من الأطفال حقوقي لناظور سيتي: تجاهل اعتماد ال ADN لإثبات النسب انتهاك لحقوق فئة مهمة من الأطفال

ناظور سيتي: مريم محو
أثار تحفظ المجلس العلمي الأعلى، عن بعض المقترحات المتعلقة بمراجعة مدونة الأسرة، لارتباطها بالمسائل القطعية في الدين، لاسيما رفضه لمسألة استعمال الخبرة الجينية للحوق النسب، تفاوتا في الآراء بين مؤيدين يرون في ذلك أمرا معقولا، كون أن الشريعة الإسلامية وضعت قواعد لحل هذه المسألة، وبين معارضين يشددون على أن في هذا الرفض، استبعادا للعلم والتطور.
وفي هذا الإطار، اعتبر مراد فوزي، رئيس جمعية حقوق وعدالة، أن تجاهل اعتماد الخبرة الجينية كدليل لإلحاق النسب، فيه انتهاك وصفه بالصارخ لحقوق فئة مهمة من الأطفال الذين ولدوا خارج إطار الزواج.
أثار تحفظ المجلس العلمي الأعلى، عن بعض المقترحات المتعلقة بمراجعة مدونة الأسرة، لارتباطها بالمسائل القطعية في الدين، لاسيما رفضه لمسألة استعمال الخبرة الجينية للحوق النسب، تفاوتا في الآراء بين مؤيدين يرون في ذلك أمرا معقولا، كون أن الشريعة الإسلامية وضعت قواعد لحل هذه المسألة، وبين معارضين يشددون على أن في هذا الرفض، استبعادا للعلم والتطور.
وفي هذا الإطار، اعتبر مراد فوزي، رئيس جمعية حقوق وعدالة، أن تجاهل اعتماد الخبرة الجينية كدليل لإلحاق النسب، فيه انتهاك وصفه بالصارخ لحقوق فئة مهمة من الأطفال الذين ولدوا خارج إطار الزواج.
وقال فوزي، في تصريح له لناظور سيتي، "إن الأطفال المولودين خارج مؤسسة الزواج لظروف اجتماعية أو شخصية خارجة عن إرادة الأم، والذين يفترض أن تحميهم التشريعات الوطنية والاتفاقيات الدولية، يحرمون من حقهم الأساسي في معرفة نسبهم وهويتهم"، الأمر الذي يخالف مبدأي المساواة وعدم التمييز المنصوص عليهما في الدستور والمواثيق الحقوقية الدولية، يسترسل مراد فوزي.
وحسب الفاعل الحقوقي، فإن مسألة الاعتراف بالخبرة الجينية كأداة قانونية لإثبات النسب، لايمثل مجرد إنصاف للأمهات والأطفال فحسب، بل هو في رأيه خطوة جوهرية نحو تحقيق العدالة الاجتماعية وحماية الأجيال المقبلة من التهميش والوصم.
وأضاف المتحدث ذاته، أن لكل طفل الحق في الانتساب إلى والده البيولوجي بغض النظر عن الظروف التي جاء فيها إلى الحياة، موردا أنه يتعين أن يكفل القانون هذا الحق دون قيد أو شرط.
ودعا المصدر، الجهات المختصة إلى إعادة النظر في هذه النقطة بما يتوافق مع متطلبات العصر والتطور العلمي، وبما يضمن ويصون حقوق الطفل التي تظل حسب تعبيره في صميم القيم الإنسانية والمجتمعية.
يذكر أن المجلس العلمي الأعلى، رفض الموافقة على ثلاث نقاط من المقترحات التي أحيلت على النظر الشرعي بشأن مراجعة مدونة الأسرة، تتعلق باستعمال الخبرة الجينية للحوق النسب، وبمسألة إلغاء العمل بقاعدة التعصيب، والتوارث بين المسلم وغير المسلم.
وحسب الفاعل الحقوقي، فإن مسألة الاعتراف بالخبرة الجينية كأداة قانونية لإثبات النسب، لايمثل مجرد إنصاف للأمهات والأطفال فحسب، بل هو في رأيه خطوة جوهرية نحو تحقيق العدالة الاجتماعية وحماية الأجيال المقبلة من التهميش والوصم.
وأضاف المتحدث ذاته، أن لكل طفل الحق في الانتساب إلى والده البيولوجي بغض النظر عن الظروف التي جاء فيها إلى الحياة، موردا أنه يتعين أن يكفل القانون هذا الحق دون قيد أو شرط.
ودعا المصدر، الجهات المختصة إلى إعادة النظر في هذه النقطة بما يتوافق مع متطلبات العصر والتطور العلمي، وبما يضمن ويصون حقوق الطفل التي تظل حسب تعبيره في صميم القيم الإنسانية والمجتمعية.
يذكر أن المجلس العلمي الأعلى، رفض الموافقة على ثلاث نقاط من المقترحات التي أحيلت على النظر الشرعي بشأن مراجعة مدونة الأسرة، تتعلق باستعمال الخبرة الجينية للحوق النسب، وبمسألة إلغاء العمل بقاعدة التعصيب، والتوارث بين المسلم وغير المسلم.

 حقوقي لناظور سيتي: تجاهل اعتماد ال ADN لإثبات النسب انتهاك لحقوق فئة مهمة من الأطفال
حقوقي لناظور سيتي: تجاهل اعتماد ال ADN لإثبات النسب انتهاك لحقوق فئة مهمة من الأطفال